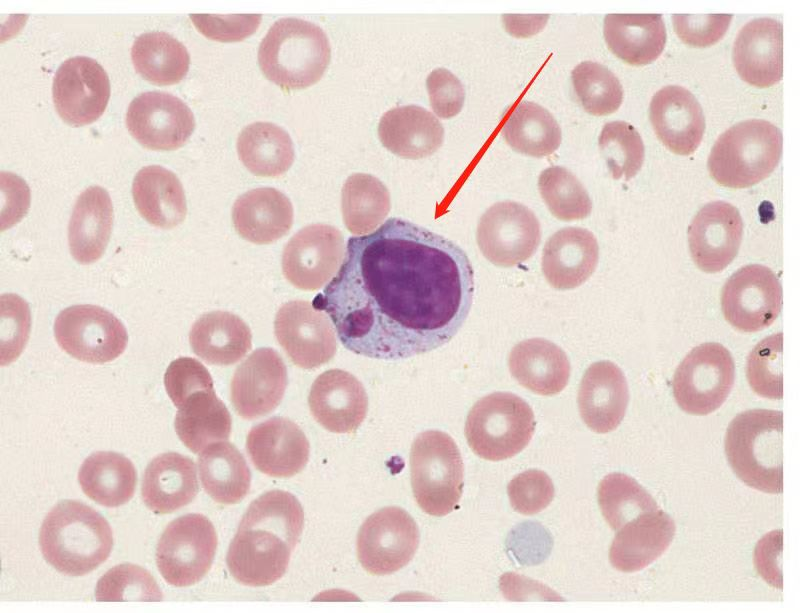

【第一百三十二期】基层检验网形态学培训
每周一次,每次几张,只要您坚持来,抽出几分钟的时间,相信您的识图能力会不知不觉的提升哦
1、箭头所指物名称?⻣髓涂片 瑞氏染色10*40

答案:肥大细胞
解析:肥大细胞的形态呈多样性,通常为圆形或者椭圆形,直径⼤约 10~15um,表⾯有许多放射状突起;细胞核呈圆形,位于细胞中央;胞浆内充满很多特异性颗粒,用碱性染料(如甲苯胺蓝)染色时呈紫红色。颗粒内含有⼤量的组胺、肝素、TNFa 和其他炎症介质,还含有超氧化岐化酶、过氧化物酶和许多酸性水解酶等。
2、箭头所指物名称?外周瑞氏染色 10*40
答案:卫星核淋巴细胞
解析:淋巴细胞形态可因电离辐射损伤而出现核固缩、核碎裂,双核淋巴细胞及含有卫星核的淋巴细胞。所谓卫星核淋巴细胞,即淋巴细胞核的旁边、胞质中出现的微小核。
3、箭头所指物名称?外周瑞氏染色 10*40
答案:血小板卫星现象
解析:偶见于EDTA 抗凝血。是指血小板黏附、围绕于中性粒细胞周围(或偶尔黏附于单核细胞)的现象,有时可见血小板吞噬现象。此时,血小板和中性粒细胞的形态和功能均正常。血小板卫星现象是血液分析仪血小板计数假性减少的原因之一。
4、图⽚所示物名称?尿液 未染色 10*40 长约 0.04-2mm
答案:轮虫
解析:轮虫并不是人体常见的寄生虫,系一种多细胞动物,属于原腔动物门 (AsChelminthes) 中一个纲,因为头部前面有一个具有纤毛的头冠,在幼稚态轮虫头冠形成类似两个“车轮”,故称轮虫,为水生生物,在尿液中检出,考虑外界水源污染所致。
5、箭头所指物名称?粪便 未染⾊ 10*40
答案:人芽囊原虫
解析:人芽囊原虫的形态主要有 4 种:空泡型、颗粒型、阿⽶巴型和包囊型。空泡型是实验室培养和粪便样品中最常见形态。球形,大小变化较大,直径范围 2-200um,平均直径 4-15um。
感谢:重医大附一院检验科和重庆市第七人民医院提供的内容。